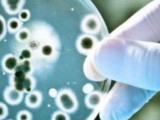

ءسىبىر
وقيعا • 29 قاڭتار, 2026
ءسىبىر ەلىگىن اتقاندار تەمىر تورعا توعىتىلدى
اقمولا وبلىسىنىڭ ءۇش تۇرعىنى زاڭسىز اۋ اۋلاعانى ءۇشىن جازاعا تارتىلدى, دەپ حابارلايدى Egemen.kz.
قوعام • 02 شىلدە, 2025
استانادا اۋرۋ مالدىڭ ەتى ساتىلعانى تۋرالى اقپارات شىندىققا جاناسپايدى
مەسسەندجەرلەر مەن الەۋمەتتىك جەلىلەردە تاراعان «استانا قالاسىنداعى “الەم” ساۋدا ورنىنا ءسىبىر جاراسىمەن اۋىرعان مالدىڭ ەتى جەتكىزىلدى» دەگەن اقپارات شىندىققا سايكەس كەلمەيدى. بۇل مالىمەتتى ۆەتەريناريالىق باقىلاۋ جانە قاداعالاۋ كوميتەتى رەسمي تۇردە جوققا شىعاردى, دەپ حابارلايدى Egemen.kz.
ايماقتار • 02 ءساۋىر, 2025
چەليابى – ءنوۆوسىبىر تاس جولىن سۋ باستى
پەتروپاۆل ماڭىنداعى «چەليابى – ءنوۆوسىبىر» حالىقارالىق اۆتوجولىنىڭ ءبىر بولىگىن سۋ باستى. تاسقىن سالدارىنان كەشە ساعات 22:00-دە اتالعان جول ۋچاسكەسىندە بارلىق كولىك تۇرلەرىنىڭ قوزعالىسىنا شەكتەۋ قويىلدى, دەپ حابارلايدى Egemen.kz.
ايماقتار • 25 قاراشا, 2024
اتىراۋدا مال بازارىنىڭ قىزمەتكەرىنەن ءسىبىر جاراسى انىقتالدى
اتىراۋ وبلىسى اكىمىنىڭ ءباسپاسوز حاتشىسى رۋسلان جۇماعازيەۆتىڭ حابارلاۋىنشا, 20 قاراشادا «اسىل-اگرو» شارۋا قوجالىعىنىڭ مال سويۋ پۋنكتى اۋماعىنا كارانتين ەنگىزىلگەن. بۇعان ءولى سيىردان ءسىبىر جاراسى بەلگىلەرىنىڭ انىقتالۋى سەبەپ بولعان, دەپ حابارلايدى Egemen.kz.
دەنساۋلىق • 24 قاراشا, 2024
اتىراۋ تۇرعىنى سيىردىڭ ولەكسەسىنەن ءسىبىر جاراسىن جۇقتىردى
اتىراۋدا «اسىل-اگرو» شارۋا قوجالىعىنىڭ مال سويۋ تسەحىندا ولگەن مالدان ءسىبىر جاراسى انىقتالعاننان كەيىن كارانتين ەنگىزىلدى. اۋرۋ جۇقتىرعان مالعا قاتىسى بولعان 17 ادام انىقتالدى. سولاردىڭ بىرىندە دەنە قىزۋى كوتەرىلىپ, ول اۋرۋحاناعا جاتقىزىلعان, دەپ حابارلايدى Egemen.kz AtyrauPress-كە سىلتەمە جاساپ.
دەنساۋلىق • 04 قاراشا, 2024
ءسىبىر جاراسىمەن سىرقاتتانعاندار سانى ەكى ەسە ازايعان
قازاقستاندا ءسىبىر جاراسىنا شالدىعۋ دەڭگەيى بىلتىرعى جىلدىڭ سوڭعى 10 ايىمەن سالىستىرعاندا ەكى ەسە تومەندەگەن, دەپ حابارلايدى Egemen.kz.
ايماقتار • 05 قىركۇيەك, 2024
الماتى وبلىسىنداعى ۇلكەن اقسۋ اۋىلىندا كارانتين ەنگىزىلدى
الماتى وبلىسىنداعى ۇلكەن اقسۋ اۋىلىندا ءسىبىر جاراسىنا بايلانىستى كارانتين ەنگىزىلدى, دەپ حابارلايدى Egemen.kz.
ايماقتار • 04 قىركۇيەك, 2024
الماتى وبلىسىنداعى ۇيعىر اۋدانىندا ۋاقىتشا شەكتەۋ ەنگىزىلدى
الماتى وبلىسى, ۇيعىر اۋدانىنداعى ۇلكەن اقسۋ اۋىلدىق وكرۋگىندە ءسىبىر جاراسىن جۇقتىرۋى مۇمكىن دەپ تانىلعان 4 ادام تىركەلدى. وسىعان بايلانىستى اۋىلدا ۋاقىتشا ۆەتەرينارلىق-سانيتارلىق شەكتەۋ ەنگىزىلدى, دەپ جازادى Egemen.kz.
شارۋاشىلىق • 09 ءساۋىر, 2024
مال قورىمدارىن سۋ باسۋدان قاۋىپ بار ما؟ مينيستر جاۋابى
ەلىمىزدىڭ اۋىل شارۋاشىعى مينيسترلىگى مال قورىمدارىن سۋ باسقان جاعدايدا دا اسا قاۋىپتى ينفەكتسيالاردىڭ پايدا بولۋ ىقتيمالدىعى جوق ەكەنىن ايتتى, دەپ حابارلايدى Egemen.kz.
ايماقتار • 26 قازان, 2023
قاراعاندى وبلىسىندا تۇتاس ءبىر اۋىل كارانتينگە جابىلدى
قاراعاندى وبلىسى, اباي اۋدانى, توپار اۋىلىنان «قاراسان» انىقتالىپ, اۋىل تولىق كارانتينگە جابىلدى. اباي قالاسىنىڭ كىرە بەرىسىنە بەكەت قويىلىپ, سانيتارلىق تەكسەرۋ جۇمىستارى قاتاڭ جۇرگىزىلىپ جاتىر. اۋىلعا جارتاس جاعىنان كىرەتىن ەكىنشى جول دا جابىلدى, دەپ حابارلايدى Egemen.kz.
قوعام • 31 تامىز, 2023
اقمولا وبلىسىنىڭ 10 تۇرعىنى ءسىبىر جاراسىن جۇقتىرعان
اقمولا وبلىسىنىڭ 12 تۇرعىنى اۋرۋحاناعا ءتۇستى. دارىگەرلەردىڭ ايتۋىنشا, 10 ادامنان ءسىبىر جاراسى انىقتالدى, تاعى 2 ادامنان اتالعان دەرتتىڭ بەلگىلەرى بايقالدى, دەپ حابارلايدى Egemen.kz اقمولا وبلىسىنىڭ سانيتارلىق-ەپيدەميولوگيالىق قاداعالاۋ باسقارماسىنا سىلتەمە جاساپ.
قازاقستان • 25 ناۋرىز, 2023
قازاقستان-ءنوۆوسىبىر اراسىنداعى رەيستەر ۋاقىتشا توقتاتىلدى
Qazaq Air اۋەكومپانياسى 26-29 ناۋرىز ارالىعىندا استانا – ءنوۆوسىبىر, وسكەمەن – ءنوۆوسىبىر باعىتتارىنداعى رەيستەردى ۋاقىتشا توقتاتتى, دەپ حابارلايدى Egemen.kz.
حوككەي • 22 اقپان, 2023
بۇگىن «بارىس» سىرت الاڭدا «سىبىرمەن» وينايدى
بۇگىن نوۆوسىبىردە قۇرلىقتىق حوككەي ليگاسىنىڭ (قحل) كەزەكتى ماۋسىمىنىڭ ماتچى وتەدى. وندا ء«سىبىر» ءوز الاڭىندا «بارىستى» قابىلدايدى, دەپ حابارلايدى Egemen.kz.
الەم • 09 اقپان, 2023
رەسەيدىڭ ءنوۆوسىبىر قالاسىندا جويقىن جارىلىس بولدى
رەسەيدىڭ ءنوۆوسىبىر قالاسىندا تاڭعى ساعات 08:00 شاماسىندا 5 قاباتتى تۇرعىن ۇيدە جويقىن جارىلىس بولدى, دەپ حابارلايدى Egemen.kz «حابار 24» ارناسىنا سىلتەمە جاساپ.
حوككەي • 17 قاڭتار, 2023
قحل: «بارىس» «سىبىردەن» جەڭىلىپ قالدى
ەلوردالىق «بارىس» قۇرلىقتىق حوككەي ليگاسىنىڭ ءۇي سەرياسىندا ء«سىبىر» كومانداسىمەن كەزدەسىپ, 1:2 ەسەبىمەن جەڭىلىپ قالدى, دەپ حابارلايدى Egemen.kz.
حوككەي • 16 قاڭتار, 2023
«بارىس» ءوز الاڭىندا «سىبىرگە» قارسى وينايدى
بۇگىن استانادا قۇرلىقتىق حوككەي ليگاسىنىڭ (قحل) تۇراقتى ماۋسىمىنىڭ ماتچى وتەدى. وندا «بارىس» ءوز الاڭىندا ء«سىبىردى» قابىلدايدى, دەپ حابارلايدى Egemen.kz.
حوككەي • 28 جەلتوقسان, 2022
قحل: «بارىس» «سىبىرمەن» كەزدەسەدى
بۇگىن ەلوردالىق «بارىس» سىرت ءالاڭدا «سىبىر» كومانداسىمەن كەزدەسەدى, دەپ حابارلايدى Egemen.kz.
حوككەي • 02 قاراشا, 2022
«بارىس» ءوز الاڭىندا «ءسىبىردى» جەڭدى
ەلوردالىق «بارىس» ءۇش ماتچتان تۇراتىن ءۇي سەرياسىن جەڭىسپەن باستادى. قحل چەمپيوناتىنىڭ ويىندارى اياسىندا استانالىقتار ءنوۆوسىبىردىڭ ء«سىبىرىن» جەڭدى, دەپ حابارلايدى Egemen.kz.
حوككەي • 01 قاراشا, 2022
«بارىس» حوككەي كوماداسى «سيبير» كلۋبىن جەڭدى
قۇرلىقتىق حوككەي ليگاسى اياسىنداعى ماتچتا استانالىق «بارىس» حوككەي كوماداسى ءوز الاڭىندا «سيبير» كومانداسىمەن وينادى, دەپ حابارلايدى Egemen.kz.
حوككەي • 01 قاراشا, 2022
بۇگىن «بارىس» «سىبىرمەن» كەزدەسەدى
بۇگىن قۇرلىقتىق حوككەي ليگاسىنىڭ تۇراقتى چەمپيوناتىنىڭ ماتچى وتەدى. وندا استانالىق «بارىس» ءنوۆوسىبىردىڭ ء«سىبىرىن» ءوز الاڭدا قابىلدايدى, دەپ حابارلايدى Egemen.kz Sports.kz-كە سىلتەمە جاساپ.
حوككەي • 27 قازان, 2022
«بارىس» نوۆوسيبيرسكىدە «سىبىرمەن» وينايدى
بۇگىن قۇرلىقتىق حوككەي ليگاسىنىڭ تۇراقتى چەمپيوناتىنىڭ كەزەكتى ماتچى وتەدى, وندا «سىبىر» استانالىق «بارىستى» قابىلدايدى, دەپ حابارلايدى Egemen.kz Sports.kz سايتىنا سىلتەمە جاساپ.
حوككەي • 18 قىركۇيەك, 2022
«بارىس» قحل ماۋسىمىندا ءۇشىنشى جەڭىسكە جەتتى
قازاقستاندىق «بارىس» حوككەي كلۋبى ءوز الاڭىندا نوۆوسىبىردەن كەلگەن ء«سىبىر» كومانداسىمەن ويناپ, قۇرلىقتىق حوككەي ليگاسىنىڭ تۇراقتى چەمپيوناتىنىڭ ءۇي سەرياسىندا ءۇشىنشى جەڭىسكە جەتتى, دەپ حابارلايدى Egemen.kz.
ايماقتار • 08 قىركۇيەك, 2022
قوستاناي وبلىسىندا ءسىبىر جاراسى انىقتالدى
قوستاناي وبلىسىنىڭ فەدوروۆ اۋدانىنا قاراستى كوسترياكوۆ اۋىلدىق وكرۋگىندە ءىرى قارا مال اراسىندا ءسىبىر جاراسىنىڭ پايدا بولۋىنا بايلانىستى كارانتين ەنگىزىلدى. بۇل تۋرالى Egemen.kz ەldala.kz سايتىنا سىلتەمە جاساپ حابارلايدى.
وقيعا • 04 تامىز, 2022
ءسىبىر تاۋتەكەسىن اتقان براكونەرلەر ۇستالدى
2-تامىز كۇنى كەشكى ساعات 19:30 شاماسىندا جوڭعار-الاتاۋ پاركىنىڭ مەملەكەتتىك ينسپەكتورلارى كەزەكتى رەيد بارىسىندا توقتى مەملەكەتتىك تابيعي قاۋمالى اۋماعىنان Toyota Land Cruiser Prado ماركالى اۆتوكولىكتى توقتاتتى, دەپ حابارلايدى Egemen.kz.
ايماقتار • 14 ءساۋىر, 2022
تۇركىستان وبلىسىنىڭ ەكى تۇرعىنىندا ءسىبىر جاراسى انىقتالدى
بۇل تۋرالى تۇركىستان وبلىسىنىڭ سانيتارلىق-ەپيدەميالىق دەپارتامەنتى ءمالىم ەتتى, دەپ حابارلايدى Egemen.kz.
ەكولوگيا • 06 ناۋرىز, 2022
ىلە الاتاۋىندا براكونەرلەر ءسىبىر ەلىگىن اتىپ العان
الماتى وبلىسىندا براكونەرلەر ءسىبىر ەلىگىن اتىپ, ونى ات قۇيرىعىنا بايلاپ قويعان, دەپ حابارلايدى Egemen.kz.
ايماقتار • 15 قىركۇيەك, 2021
سقو-دا ەلىك اتقان براكونەرلەر ۇستالدى
سولتۇستىك قازاقستان وبلىسىنىڭ پوليتسەيلەرى ەرەكشە قورعالاتىن تابيعي ايماقتا زاڭسىز اڭ اۋلاعان كۇدىكتىلەردى ۇستادى, دەپ حابارلايدى Egemen.kz.
ايماقتار • 08 قىركۇيەك, 2021
اياگوز اۋدانىنىڭ بىرنەشە تۇرعىنى ءسىبىر جاراسىن جۇقتىردى
قاۋىپتى ينفەكتسيا اياگوز اۋدانىنىڭ مايلين اۋىلىندا شىلدە ايىندا تىركەلگەن, دەپ حابارلايدى Egemen.kz.
ايماقتار • 31 تامىز, 2021
ءسىبىر جاراسىنا بايلانىستى اقجار اۋدانى ءتورت ايماققا ءبولىندى
اقجار اۋدانىندا ءىرى قارا مال اراسىندا اسا قاۋىپتى ءسىبىر جاراسى اۋرۋىنىڭ انىقتالۋىنا بايلانىستى سولتۇستىك قازاقستان وبلىسى باس مەملەكەتتىك ۆەتەريناريالىق-سانيتاريالىق ينسپەكتورىنىڭ حاتىنا سايكەس, اكىمدىكتىڭ قاۋلىسى قوعامدىق تالقىلاۋعا شىعارىلدى, دەپ حابارلايدى Egemen.kz.
وقيعا • 27 تامىز, 2021
سولتۇستىك قازاقستاندا ءسىبىر جاراسىنىڭ وشاعى انىقتالدى
بۇل – جانۋارلار مەن ادامدار ءۇشىن اسا قاۋىپتى جۇقپالى اۋرۋ, دەپ جازادى Egemen.kz سقو سانيتاريالىق-ەپيدەميولوگيالىق باقىلاۋ دەپارتامەنتىنىڭ رەسمي سايتىنا سىلتەمە جاساپ.